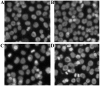
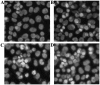

Effects of orientin and vitexin from Trollius chinensis on the growth and apoptosis of esophageal cancer EC-109 cells
- PMID: 26622901
- PMCID: PMC4580036
- DOI: 10.3892/ol.2015.3618
Effects of orientin and vitexin from Trollius chinensis on the growth and apoptosis of esophageal cancer EC-109 cells
Abstract
Orientin and vitexin are the monomers of total flavonoids in Trollius chinensis Bunge. Orientin and vitexin have the same chemical constitution. Modern studies on pharmacology have indicated that the total flavonoids of this plant have antitumor actions. The aim of the present study was to investigate the effects of orientin and vitexin on the growth and apoptosis of EC-109 cells, to investigate the expression of p53 and B-cell lymphoma (bcl-2), and to discuss the associated antitumor activity, in vitro. This data provides experience for the basis of the selection and structure-activity associations of antineoplastic agents, and analysis of the efficacy of the total flavonoids in Trollius chinensis. In this study, EC-109 cells in the logarithmic growth phase were treated with different concentrations of orientin and vitexin. The inhibitory effect on cell growth and proliferation was detected by MTT method. Cell nuclei were assayed by the cell death detection using Hoechst 33258 staining, cell apoptosis was detected by DNA agarose gel electrophoresis, and the apoptosis rate of the EC-109 cells was examined using an Annexin V-fluorescein isothiocyanate/propidium iodide double-labeled technique of flow cytometry (FCM). The protein expression of p53 and bcl-2 in the EC-109 cells was detected by FCM. Orientin and vitexin exhibited marked inhibitory effects on the proliferation of the EC-109 cells. The inhibition rate increased with the increase in concentration and reaction time, and orientin and vitexin were able to induce the apoptosis of the EC-109 cells. The gene expression levels of p53 and bcl-2 were upregulated and downregulated, respectively. Additionally, the antitumor effects of orientin were stronger than that of vitexin using the same concentration. These experimental findings indicated that orientin and vitexin engender antitumor effects that may be associated with the regulation of the apoptosis-related gene expression of p53 and bcl-2. Therefore, orientin and vitexin may serve as therapeutic agents for the treatment of esophageal cancer.
Keywords: EC-109; apoptosis; orientin; vitexin.
Figures

References
-
- Zhang XG. Risk factors and prevention research progress of esophagus cancer. World Chin J Dig. 2009;17:670–680. (In Chinese)
-
- Li XK, Fan QX. The research progress of esophageal cancer drug therapy. World Chin J Dig. 2012;35:3482–3487. (In Chinese)
-
- Kelsen D, Ajani J, Ilson D, Daugherty K, Pazdur R. A phase ii trial of paclitaxel (Taxol) in advanced esophageal cancer: Preliminary report. Semin Oncol. 1994;5:44–48. (Suppl 8) - PubMed
-
- Li LQ. The geographical distribution of buttercup family of Trollius chinensis. Acta Phytotaxonomica Sinica. 1995;33:535–537. (In Chinese)
-
- Li YL, Ye SM, Wang LY, Cen YZ. Isolation and biological activity of proglobeflowery acid from Trollius chinensis Bunge. J Jinan Univ. 2002;23:124–126. (In Chinese)
LinkOut - more resources
Full Text Sources
Other Literature Sources
Research Materials
Miscellaneous